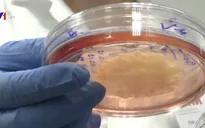
Sản phẩm thịt từ phòng thí nghiệm đầu tiên tại Nga

Tổng thống Mỹ Donald Trump hôm 28/4 đã ký một sắc lệnh hành pháp sử dụng Đạo luật sản xuất quốc phòng, cho phép việc duy trì hoạt động này.
Theo sắc lệnh này, việc đóng cửa các nhà máy chế biến thịt đe dọa chuỗi cung ứng thịt gia súc và gia cầm trên toàn quốc.
Trước đó, các công ty chế biến thịt lớn nhất thế giới đã ngừng hoạt động ở khoảng 20 lò mổ và các nhà máy chế biến ở Bắc Mỹ, do nhân viên các công ty này bị nghi ngờ mắc bệnh COVID-19.
Đạo luật trên được soạn thảo nhằm bảo vệ về mặt pháp lý đối với các công ty trên khỏi các vụ kiện mà nhân viên có thể khởi xướng, nếu họ mắc bệnh do vẫn phải đi làm.
* Mời quý độc giả theo dõi các chương trình đã phát sóng của Đài Truyền hình Việt Nam trên TV Online!

Bình luận (0)